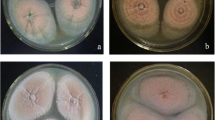

Abstract
Aspergillus oryzae G15 was cultured on Czapek yeast extract agar medium containing different concentrations of copper and lead to investigate the mechanisms sustaining metal tolerance. The effects of heavy metals on biomass, metal accumulation, metallothionein (MT), malondialdehyde (MDA), superoxide dismutase (SOD), catalase (CAT), and peroxidase (POD) were evaluated. Cu and Pb treatment remarkably delayed sclerotial maturation and inhibited mycelial growth, indicating the toxic effects of the metals. Cu decreased sclerotial biomass, whereas Pb led to an increase in sclerotial biomass. G15 bioadsorbed most Cu and Pb ions on the cell surface, revealing the involvement of the extracellular mechanism. Cu treatment significantly elevated MT level in mycelia, and Pb treatment at concentrations of 50–100 mg/L also caused an increase in MT content in mycelia. Both metals significantly increased MDA level in sclerotia. The variations in MT and MDA levels revealed the appearance of heavy metal-induced oxidative stress. The activities of SOD, CAT, and POD varied with heavy metal concentrations, which demonstrated that tolerance of G15 to Cu and Pb was associated with an efficient antioxidant defense system. In sum, the santioxidative detoxification system allowed the strain to survive in high concentrations of Cu and Pb. G15 depended mostly on sclerotial differentiation to defend against Pb stress.
Similar content being viewed by others
Explore related subjects
Discover the latest articles, news and stories from top researchers in related subjects.Avoid common mistakes on your manuscript.
Introduction
Along with the rapid development of industry and agriculture, heavy metal pollution has become one of the most important ecological problems on world scale (Amarasinghe and Williams 2007). Contaminant metals (e.g., lead and copper) can often accumulate in considerable amounts in plants, animals, and microorganisms (Mani and Kumar 2014). Lead contamination is known to have a wide range of adverse effects on growth and metabolism of fungi. Copper plays a vital role in maintaining normal metabolism in fungi, but it exerts toxic effects when present in excess (Baldrian 2003; Luna et al. 2015). It has been reported that Cu and Pb had inhibitory effects on spore germination (Rózycki 1992) and mycelia growth (Rózycki 1993) of Cylindrocarpon destructans. Gabriel et al. (1994) found that Schizophyllum commune formed black mycelial pellets in Pb-containing media, while the controls were creamy. Krumova et al. (2009) showed that Cu caused visible inhibition in mycelia growth and conidiospore formation of Humicola lutea. The most widely studied consequence of heavy metal toxicity in fungi is the overproduction of reactive oxygen species (ROS). Excess oxygen free radicals induced by heavy metal lead to lipid peroxidation (Krumova et al. 2009; Luna et al. 2015; Zhao et al. 2015), membrane dismantling (Krumova et al. 2012; Luna et al. 2015), and damage to protein and DNA (Bellion et al. 2006) in fungi. There is also evidence that ROS plays an important role in fungal differentiation. It has been reported that hyperoxidant states were the driving force that triggered microbial cell differentiation (Hansberg and Aguirre 1990; Fang et al. 2002). Georgiou et al. (2006) summarized the studies on sclerotial development and pointed out that sclerotial differentiation in filamentous fungi was induced by oxidative stress.
Fungi species vary in their tolerability to heavy metals and in the corresponding detoxification mechanisms. Many fungi strains have been shown to possess an ability to survive in high concentrations of toxic heavy metals (Gadd 1993; Fomina et al. 2005; Zafar et al. 2007). Generally, the metal tolerance mechanisms of fungi are described as extracellular (cell wall binding) and intracellular (chelation and/or sequestration) (Bellion et al. 2006). Metallothioneins (MT) are typical metal-binding proteins, which have been proven to be a kind of metal stress biomarker in aquatic fungi (Guimarães-Soares et al. 2006). Some studies showed that antioxidative systems, which protect the fungi from oxidative damage, involve in the detoxification of copper (Krumova et al. 2009; Luna et al. 2015; Zhao et al. 2015). However, the lead-induced antioxidant enzyme response in fungi has been poorly researched. Among the antioxidases, superoxide dismutase (SOD EC 1.15.1.1), catalase (CAT EC 1.11.1.6), and peroxidase (POD EC 1.11.1.7) play essential roles in the scavenging of reactive oxygen. SOD, the key member of the antioxidative detoxification enzymes, dismutates superoxide radical (O2 −) to hydrogen peroxide (H2O2) (Fridovich 1998). The hydrogen peroxide in cells is regulated by a variety of enzymes, of which the most important ones are CAT and POD (Rusina et al. 2004). Moreover, metallothioneins are another class of antioxidants, which are able to eliminate ROS (Guimarães-Soares et al. 2006).
It is widely believed that sclerotia can survive under adverse conditions that are too severe for the mycelia (Willetts 1971; Erental et al. 2008). However, there are no sufficient studies investigating whether the heavy metal detoxification mechanisms change along with the sclerotial differentiation. In this work, we investigated the response to copper and lead exposure in A. oryzae G15. First, the heavy metal accumulations and the resulting morphological changes of G15 were examined. Then, two stress biomarker (malondialdehyde and MT) levels and the antioxidant enzyme defense response (SOD, CAT, POD) of the strain when exposed to Cu and Pb were evaluated.
Materials and methods
Strain and incubation
Strain G15 was isolated from forest soil of Pangquangou National Nature Reserve, Shanxi, China, and identified as Aspergillus oryzae. The collection number of strain G15 in the China Center for Type Culture Collection (Wuhan University, Wuhan, China) is CCTCC AF2016006. In this work, Czapek yeast extract agar (CYA) was used for the culture of strain G15. The media supplemented with 25, 50,100, 200, and 300 mg/L of Cu and Pb ions were used to determine the tolerance and response of G15 to copper and lead. A grain of sclerotium was inoculated at the center of a 9-cm Petri dish containing 25 mL medium or on a cellophane membrane placed on top of 25 mL of medium in a 9-cm Petri dish. The sclerotia as inoculum were obtained from 10-day-old potato dextrose agar plate cultures. Each plate was incubated at 30 °C for 10 days in the dark. Then, the sclerotia treated with heavy metals at concentrations of 0 (control) and 100 mg/L were separated using an inoculating needle and prepared as SEM samples and examined using scanning electron microscopes (SEM: TESCAN, MAIA 3).
The stock solutions of Cu and Pb ions (4 g/L) were made in double distilled water using CuSO4·5H2O and Pb(NO3)2. The stock solution of heavy metals was sterilized separately through a Millipore filter (0.22 μm) and added to sterilized medium.
DNA extraction, PCR amplification, and sequencing
The mycelia for total genomic DNA extraction were acquired through the vibrant liquid Czapek yeast extract medium. DNA extraction was performed according to the E.Z.N.A.™ Fungal DNA Miniprep Kit program. The nuclear ribosomal ITS1–5.8S–ITS2 region was amplified with primers ITS1 and ITS4 from isolated fungus DNA. The PCR products were sequenced by the Sanger method in Sangon Biotech (Shanghai). Then, the sequence was compared with the NCBI database using BLAST. The phylogenetic tree based on the neighbor-joining method (Saitou and Nei 1987) was performed using MEGA version 5. Distances were calculated according to Kimura’s two-parameter model. A bootstrap was conducted with 1000 replications. Sequences of related taxa were obtained from the GenBank database.
Estimation of biomass and metal accumulation
The mycelia cultured for 4 days and sclerotia cultured for 7 days on the cellophane membrane placed on agar surfaces were separated using an inoculating needle and washed thoroughly with ddH2O. Sclerotia and mycelia were dried at 40 °C to constant mass to determine mycelia and sclerotia biomass. Then, these resulting products were collected and used in further research.
The dried sclerotia and mycelia were agitated with 0.1 mol/L EDTA–Na2 for 30 min to remove Cu and Pb ions on the cell surface. Then, the sclerotia and mycelia were digested with nitric acid and perchloric acid (4:1 ratio) to analyze the heavy metal ions absorbed in the cell. Cu and Pb contents in supernatants were measured to determine the extent of cell wall-bound metal ions. The heavy metal content in supernatants and digested liquid was estimated by atomic absorption (Scientific Atomic Absorption Spectrophotometer AA240FS, Varian). The content of Cu and Pb in mycelia and sclerotia was calculated using the following equation:
where Q is the content of Cu and Pb in mycelia and sclerotia (mg/g), C is the concentration of heavy metal in digested liquid (mg/L), V is the volume of the supernatants and digested liquid (mL), and W is the dry mass of the mycelia and sclerotia (g).
Determination of metallothioneins
Mycelia or sclerotia (1.0 g DW) were homogenized in liquid nitrogen in a mortar. The resultant paste was suspended in 10 mL of ice-cold 0.1 mol/L Tris–HCl buffer (pH 8.6, 0.2 mmol/L phenylmethanesulfonyl fluoride, 1 mg/L leupeptin, 2% 1,4-dithiothreitol) for 3 h. Then, the homogenate was centrifuged at 12000 RPM for 30 min at 4 °C to eliminate cell debris. The supernatant was heated in water baths at 90 °C for about 5 min and centrifuged at 12000 RPM for 20 min. The supernatant was kept at −20 °C and used for the determination of MT. MT contents were measured using enzyme-linked immunosorbent assay (ELISA). The determination was performed according to the MT ELISA Kit program (Shanghai Enzyme-Linked Biotechnology Co.)
Determination of lipid peroxidation
The measurement of thiobarbituric acid reactive substances (TBARS), such as malondialdehyde (MDA), has become the method for monitoring lipid peroxidation. A modified method described by Ohkawa et al. (1979) for TBARS quantification was used.
Dry mycelia or sclerotia (0.5 g) were grinded with 5.0 mL of 20% trichloroacetic acid (TCA). MDA was obtained after centrifugation at 12000 RPM for 5 min. Supernatant was blended with the same volume of 0.5% (w/v) thiobarbituric acid (TBA) reagent (1% TBA solution in 0.05 mol/L NaOH was prepared and mixed with 20% (w/v) TCA in 1:1 proportion) in the Eppendorf tube. The tubes were heated at 95 °C for 30 min and finally cooled on ice for 10 min and centrifuged at 2000 RPM for 5 min. The content of TBARS in the suspensions was measured at 532 and 450 nm. The results were expressed as micromoles of MDA per gram of mycelia or sclerotia.
Determination of antioxidant enzymes
Mycelia or sclerotia (2.0 g DW) were homogenized in 10 mL of 50 mmol/L phosphate buffer (pH 7.8, 0.2 mmol/L EDTA–Na2, 4% polyvinylpyrrolidone) in a pre-chilled mortar under liquid nitrogen. The homogenate was centrifuged at 12000 RPM for 20 min at 4 °C. The supernatant was used for the determination of SOD, CAT, and POD. Protein concentration in the supernatant was assayed according to the Kjeldahl method (Bradstreet 1965; McClements 2007). The neutralization and titration tests were performed in an Automatic Kjeldahl instrument (Jinan, China).
SOD activity was determined according to Beauchamp and Fridovich (1971), with the same procedure as published earlier by Zhao et al. (2015). One unit of SOD was defined as the amount of enzyme which inhibited the reduction of nitroblue tetrazolium chloride (NBT) by 50%.
CAT activity was assayed by the method of Goth (1991). The assay mixture (3 mL) consisted of 50 mmol/L phosphate buffer (pH 7.0), 2 mmol/L H2O2, and 100 μL enzyme extract. The temperature was maintained at 37 °C using a water bath. One minute later, the reaction was stopped with 1.0 mL of 30 mmol/L diammonium molybdate. The absorbance of the yellow complex compound (peroxy molybdate) was measured at 405 nm. One unit of CAT activity was defined as 1 μmol H2O2 decomposed per milligram of protein per second.
POD activity was assayed according to Boldt et al. (1984), with minor modifications. The reaction mixture (300 μL) consisted of 0.15 mol/L sodium acetate–acetic acid buffer (pH 5.0), 0.07% tetramethylbenzidine (TMB), 0.1% methylbenzene, and 100 μL exudates. The reaction was started by adding 100 μL of 2% chilled H2O2. The absorbance of the reaction product was measured at 630 nm. One unit of POD activity was defined as absorbance change 0.01 per minute.
Statistics
All experiments were replicated in three times, and the data are presented as the arithmetic mean ± standard error. Data were analyzed using the SPSS statistics (17.0 edition). One-way ANOVA followed by Tukey’s test was used to evaluate the significant differences at the 1% level of confidence, and bivariate correlation analysis was applied to analyze the relationship between the values.
Results
Identification and sequencing of strain G15
Microscopic examination showed that fungus G15 formed chains of spores from radiate conidiophores, which is characteristic of fungal genus Aspergillus. The phylogenetic tree from rDNA-ITS sequences indicated that strain G15 showed the highest similarity to A. oryzae (Fig. 1). Therefore, the strain was identified as A. oryzae G15. The GenBank accession number for the ITS sequence of A. oryzae G15 is KT274812.
Effects of heavy metals on growth and sclerotial differentiation
The macroscopic colony characters of G15 were changed by the treatments of copper and lead (Fig. 2). The diameters of colonies treated with copper ions were significantly decreased when compared to control. The spore formation and mycelia growth were inhibited by Pb treatment. At 25 and 100 mg/L Pb, the sclerotia became lighter in color. Moreover, lead treatment moved the time of sclerotial initiation ahead by 12–24 h and delayed sclerotial maturation by 24–60 h. Cu treatment had no effect on time of sclerotial initiation, but it delayed sclerotial maturation by 24–48 h. SEM micrographs of untreated and heavy metal-treated sclerotia (cultured for 10 days) are shown in Fig. 3. It was observed that the natural sclerotia had a smooth surface and closely intertwined hyphae (Fig. 3a). Cu (100 mg/L) treatment had influence on the density of intertwined hyphae (Fig. 3b). Yet, its impact on sclerotial differentiation was less than in Pb treatment. Obvious spaces could be observed in the sclerotia exposed to 100 mg/L Pb ions (Fig. 3c).
Colonies of A. oryzae G15 on a CYA, b CYA + 25 mg/L Cu ions, c CYA + 50 mg/L Cu ions, d CYA + 100 mg/L Cu ions, e CYA + 200 mg/L Cu ions, f CYA + 300 mg/L Cu ions, g CYA + 25 mg/L Pb ions, h CYA + 50 mg/L Pb ions, i CYA + 100 mg/L Pb ions, j CYA + 200 mg/L Pb ions, and k CYA + 300 mg/L Pb ions at 30 °C, after 7 days. Petri dish size = 9 cm in diameter
Estimation of biomass of mycelia and sclerotia
With the increase of Cu concentration, mycelia and sclerotia of G15 decreased in biomass (Table 1). It could be found that the biomass had a correlation with the Cu contents in media (Rmycelia = −0.985, Rsclerotia = −0.979). Compared to the control group, sclerotial biomass was declined significantly by 88.4%, and mycelial biomass was declined by 33.9% at 300 mg/L Cu. In the case of lead treatment, the mycelial biomass was decreased, while the sclerotial biomass was increased (except for 300 mg/L Pb) when compared to control. At 300 mg/L Pb ions, a 24.6% decrease in sclerotia biomass was observed. These results showed that the effect of lead on sclerotial differentiation was also concentration-dependent. A lower concentration of heavy metal was more favorable to sclerotia formation.
Heavy metal accumulation in mycelia and sclerotia
The accumulation of copper and lead was assessed by determining Cu and Pb contents in the cell and on the cell surface. The results showed that accumulated Cu and Pb increased with the enhancement of heavy metal concentrations. The accumulated copper in mycelia and sclerotia treated with 300 mg/L Cu reached respectively 12- and 10-fold in those treated with 25 mg/L Cu (Table 2). In the case of lead treatment, these figures were 10- and 8-fold (Table 3). The contents of copper and lead in sclerotia were relatively more than those in mycelia. The results also indicated that most heavy metal ions were adsorbed on the cell surface rather than in the cell interior. The proportion of lead ions that bioaccumulated inside the cells hovered around 20%. In addition, the detected copper in mycelia and sclerotia grown on control media were attributed to the yeast extract in CYA.
Effects of heavy metals on metallothioneins
MT levels in mycelia treated with Cu were elevated significantly when compared to the control (Fig. 4a). Furthermore, the contents were correlated with the copper concentrations in media (R = 0.876). Figure 4b shows that MT reached its maximum level (up to 1.4-fold when compared to the control) in mycelia treated with 100 mg/L Pb ions. Then, the MT contents decreased, but the decreases were not significant when compared with the control. The results also indicated that heavy metal treatment resulted in no significant changes in MT levels in sclerotia. The MT concentrations were about 10 μg/g in all the sclerotia examined.
Effects of heavy metals on total lipid peroxidation
The effects of heavy metal on lipid peroxidation, measured as MDA production, were observed. The results showed that Cu treatment increased significantly the MDA contents in mycelia (Fig. 5a). At 50 mg/L Cu ions, the peak of MDA content was observed. In the case of sclerotia, MDA contents elevated dramatically with the addition of Cu ions. The MDA content in sclerotia treated with 200 mg/L Cu ions increased around 2.5-fold when compared to the control. Pb treatment caused no significant changes in MDA contents in mycelia (Fig. 5b), while the contents in sclerotia increased dramatically at all concentrations of Pb. The maximum value of MDA content (up to 3.7-fold) was observed in sclerotia treated with 100 mg/L Pb ions.
Effects of heavy metals on antioxidant enzymes
SOD activities in mycelia and sclerotia were elevated due to copper in media (Fig. 6a). A strong positive correlation was found between SOD levels and Cu concentrations in media (Rmycelia = 0.837, Rsclerotia = 0.733). On the contrary, SOD activities in samples exposed to Pb were decreased significantly when compared to the control (Fig. 6b). At 300 mg/L Pb ions, the SOD activity in mycelia was decreased by 33.3% and that in sclerotia was decreased by 98.2%. The results also indicated that the values of SOD activities had a negative correlation with the lead concentrations (Rmycelia = −0.668, Rsclerotia = −0.897).
CAT activities in samples exposed to Cu were all promoted when compared to the control (Fig. 6c). In mycelia, CAT activity reached its maximum value of 3.96 U/mg protein per min at 50 mg/L copper, then it declined with the enhancement of copper concentrations. In sclerotia, catalase activity increased by 50% at 100–200 mg/L Cu ions as compared with the control. Furthermore, the presence of copper at a concentration of 300 mg/L caused a significant decrease in CAT activity compared to the concentration of 100 mg/L. The effects of Pb on CAT activity are shown in Fig. 6d. In mycelia, no significant change in CAT activity was noticed at 25 mg/L Pb. Further elevated Pb concentrations (50 to 300 mg/L) led to significant decreases in CAT activity. As compared with the control, CAT activity in mycelia exposed to 300 mg/L Pb decreased by 57.4%. In sclerotia, CAT activity was also significantly reduced because of Pb treatment. At 300 mg/L Pb ions, CAT activity decreased by 68.5% when compared to the control.
As could be seen from Fig. 6e, POD activity in mycelia reached the highest level at 100 mg/L Cu (1.62 U/mg protein per minute), while further elevated Cu concentrations from 100 to 300 mg/L led to the decline in POD activity. The results also showed that the presence of Cu at concentrations of 25–200 mg/L had no obvious effect on the activity in sclerotia, and a significant reduction (fell to 43% when compared to the control) was observed at 300 mg/L Cu. As shown in Fig. 6f, the presence of lead at a concentration of 25 mg/L caused no significant change in POD activity in mycelia. Further, elevated Pb concentrations significantly promoted CAT activities. The peak of POD activity was observed in mycelia exposed to 50 mg/L Pb, with a significant increase (up to 1.3-fold) when compared to the control. In the case of sclerotia, Pb treatment slightly enhanced POD activities, while the trend was not obvious.
Discussion
Fungi growing in high heavy metal concentrations usually changed with their physiological and morphological features and the process of growth and development (Baldrian 2003; Baptista et al. 2009; Krumova et al. 2009). In this study, the results obtained revealed that Cu and Pb accumulation in A. oryzae G15 produced toxic effects, as indicated by the reduction in colony diameter, spore density, and mycelia biomass. The tolerance of fungi to high concentrations of toxic metals was achieved by extracellular and intracellular detoxification mechanisms (Bellion et al. 2006). For G15, most of the heavy metals were bound to the cell surface rather than bioaccumulated in cells. These results revealed that the extracellular mechanism (binding ions on the cell surface) was involved in the tolerance of G15 to copper and lead. Furthermore, the increasing concentrations of heavy metals resulted in a phenomenal growth in the number of accumulated copper and lead, which showed that G15 might be able to remove Cu and Pb from the environment. Similar findings have been observed in Aspergillus niger, Macrolepiota procera, and several mycorrhizal fungi (Dursun et al. 2003; Fomina et al. 2005; Baptista et al. 2009).
Despite the cell wall-binding abilities of G15, about 20 to 40% of the heavy metals entered into the cell. This indicated the presence of the intracellular system for heavy metal detoxification. Induction of oxidative stress in fungi exposed to heavy metal has been well documented (Baptista et al. 2009; Krumova et al. 2009; Luna et al. 2015; Zhao et al. 2015). In our work, MDA accumulation, an indicator of oxidative stress, was increased by Cu and Pb treatment. This meant that excess lead and copper were able to induce ROS production in mycelia and sclerotia. Antioxidant enzymes in fungi played vital roles in the alleviation of lipid peroxidation and elimination of free radicals. In our work, the activity of SOD was significantly increased by Cu treatment, which could be due to the excess of induced O2 −. The results were in accord with the findings observed in Cu-treated H. lutea (Krumova et al. 2009) and A. niger (Luna et al. 2015). The data obtained showed that Cu ions in different concentrations improved CAT activity in different degrees, and 50 and 100 mg/L Cu ions were the most effective ones for mycelia and sclerotia, respectively. These results suggested that an alternative pathway for H2O2 decomposition, namely, glutathione reductase, could be activated when exposed to high Cu concentration. The present data were consistent with the results observed in A. niger exposed to copper stress (Bučková et al. 2005; Luna et al. 2015). The effect of heavy metal on POD in fungi was rather poorly researched when compared to SOD and CAT. In our work, induction of POD was also detected at lower copper concentrations, while Cu in the relatively high level caused loss in the activities. The declined POD activity could be attributed to the low levels of H2O2 as a result of the increased CAT activity and glutathione reductase. All these results indicated that SOD, CAT, and POD played important roles in the detoxification of copper via scavenging free radicals. In the case of Pb treatment, a significant decline in SOD activity was observed, and the activity was inversely related to Pb concentration. According to Gajewska et al. (2006), SODs were metalloenzymes containing Fe2+, Cu2+, Zn2+, or Mn2+ in their prosthetic groups. In this work, Pb ions probably inactivated SOD by replacing the prosthetic group-bound ions. CAT activity in G15 was also decreased, which could be ascribed to the ROS-induced inhibition as a result of the weakening levels of SOD (Todorova et al. 2008). Similar results have been found in A. niger under Cd stress (Todorova et al. 2008). On the other hand, Pb ions in cells might result in the inactivation of CAT by inactivating the enzyme-bound heme group (Gajewska et al. 2006), while Pb treatment promoted the POD activity, which could be due to the excess H2O2 induced by lead. The obtained results indicated that SOD and CAT failed to protect G15 from cellular oxidative damage induced by Pb stress, and POD performed a significant part of the antioxidant enzymatic defense system. In addition, heavy metal treatment had different effects on mycelia and sclerotia. It has been reported that both exposure time and metal concentrations affected the activities of antioxidant enzymes in M. procera (Baptista et al. 2009) and A. niger (Luna et al. 2015) significantly. Thereby, these differences might be connected with the collection time of mycelia and sclerotia.
Metallothioneins in fungi were able to bind metal and also to eliminate ROS (Guimarães-Soares et al. 2006). It has been reported that MT could be induced by heavy metals in many fungi, including Beauveria bassiana, Fontanospora fusiramosa, Flagellospora curta, and various macrofungi (Bellion et al. 2006; Guimarães-Soares et al. 2006). However, there were a few studies about the effects of heavy metals on MT levels in Aspergillus. In the case of mycelia, copper treatment elevated the MT levels significantly in a concentration-dependent manner. Lead treatment with concentrations of 50 and 100 mg/L also significantly increased the MT contents. In the case of sclerotia, MT levels were unaffected by copper and lead. The data demonstrated that MT was mostly activated early (4 days) to scavenge ROS and chelate metal ions. In addition, Pb treatment had a smaller effect on MT levels, which could be due to its lower affinity for MT than Cu (Wang et al. 2009).
Georgiou et al. (2006) reported that sclerotial differentiation in fungi was triggered by oxidative stress which would be induced by heavy metals. Papapostolou et al. (2014) showed that H2O2 in Sclerotium rolfsii and Sclerotinia sclerotiorum could suppress terminal sclerotial differentiation in low concentration and promote sclerotial differentiation in high concentration. In this work, levels of antioxidant enzymes and MT in sclerotia were lower than in the mycelia, suggesting the lower ROS in sclerotia. Cu treatment delayed sclerotial maturation and reduced sclerotial biomass, which could be due to the low H2O2 content in sclerotia as a result of high levels of antioxidant enzymes and MT. In the case of lead treatment, it could be speculated that the antioxidant enzymes and MT were not sufficient to maintain a low level of H2O2 in sclerotia. Thereby, the lead stress resulted in increases in sclerotial biomass.
Conclusion
It was observed that there were toxic effects of copper and lead on growth and differentiation of A. oryzae G15, and significant decreases in mycelial biomass were found. In this study, the cell wall of the strain provided the first line of defense against toxicity. Increased levels of MT have been observed in mycelia exposed to metals, suggesting its involvement in heavy metal detoxification. The lipid peroxidation, measured as MDA, was enhanced by Cu and Pb treatment, indicating that the metals caused oxygen damage in G15 and might affect sclerotial development by inducing ROS production. The strain showed activities of superoxide dismutase, catalase, and peroxidase to combat oxidative damage. Cu treatment enhanced the antioxidant enzyme activities and reduced sclerotial biomass, which indicated that the strain was protected efficiently from the copper-induced damage. Pb treatment inhibited the activities of SOD and CAT and promoted the sclerotial differentiation, suggesting that the responses of G15 were insufficient to protect the cells against lead-induced damage. These data might be conducive to the further study on metal tolerance mechanisms in sclerotiogenic fungi.
References
Amarasinghe BMWPK, Williams RA (2007) Tea waste as a low cost adsorbent for the removal of Cu and Pb from wastewater. Chem Eng J 132:299–309
Baldrian P (2003) Interactions of heavy metals with white-rot fungi enzyme. Microb Tech 32:78–91
Baptista P, Ferreira S, Soares E, Coelho V (2009) Tolerance and stress response of macrolepiota procera to nickel. J Agric Food Chem 57:7145–7152
Beauchamp CO, Fridovich I (1971) Superoxide dismutase: improved assays and an assay applicable to acrylamide gels. Anal Biochem 44:276–287
Bellion M, Courbot M, Jacob C, Blaudez D, Chalot M (2006) Extracellular and cellular mechanisms sustaining metal tolerance in ectomycorrhizal fungi. FEMS Microbiol Lett 254:173–181
Boldt J, Alliegro MC, Schuel H (1984) A separate catalase and peroxidase in sea urchin sperm. Gamete Res 10:267–281
Bradstreet RB (1965) The Kjeldahl method for organic nitrogen. Academic Press, New York and London
Bučková M, Godočíková J, Šimonovičová A, Polek B (2005) Production of catalases by Aspergillus niger isolates as a response to pollutant stress by heavy metals. Curr Microbiol 50:175–179
Dursun AY, Uslu G, Cuci Y, Aksu Z (2003) Bioaccumulation of copper(II), lead(II) and chromium(VI) by growing Aspergillus niger. Process Biochem 38:1647–1651
Erental A, Dickman MB, Yarden O (2008) Sclerotial development in Sclerotinia sclerotiorum: awakening molecular analysis of a “dormant” structure. Fungal Biol Rev 22:6–16
Fang GC, Hanau RM, Vaillancourt L (2002) The SOD2 gene, encoding a manganese-type superoxide dismutase, is up-regulated during conidiogenesis in the plant-pathogenic fungus Colletotrichum graminicola. Fungal Genet Biol 36:155–165
Fomina MA, Alexander IJ, Colpaert JV, Gadd GM (2005) Solubilization of toxic metal minerals and metal tolerance of mycorrhizal fungi. Soil Bio Biochem 37:851–866
Fridovich I (1998) Oxygen toxicity: a radical explanation. J Exp Biol 201:1203–1209
Gabriel J, Mokrejš M, Bílý J, Rychlovský P (1994) Accumulation of heavy metals by some wood-rotting fungi. Folia Microbiol 39:115–118
Gadd GM (1993) Interactions of fungi with toxic metals. New Phytol 124:25–60
Gajewska E, Skłodowska M, Słaba M, Mazur J (2006) Effect of nickel on antioxidative enzyme activities, proline and chlorophyll contents in wheat shoots. Biol Plantarum 50:653–659
Georgiou CD, Patsoukis N, Papapostolou I, Zervoudakis G (2006) Sclerotial metamorphosis in filamentous fungi is induced by oxidative stress. Integr Comp Biol 46:691–712
Goth L (1991) A simple method for determination of serum catalase activity, and revision of reference range. Clin Chim Acta 196:143–151
Guimarães-Soares L, Felícia H, Bebianno MJ, Cássio F (2006) Metal-binding proteins and peptides in the aquatic fungi Fontanospora fusiramosa and Flagellospora curta exposed to severe metal stress. Sci Total Environ 372:148–156
Hansberg W, Aguirre J (1990) Hyperoxidant states cause microbial cell-differentiation by cell isolation from dioxygen. J Theor Biol 142:201–221
Krumova EZ, Pashova SB, Dolashka-Angelova PA, Stefanova T, Angelova MB (2009) Biomarkers of oxidative stress in the fungal strain Humicola lutea under copper exposure. Process Biochem 44:288–295
Krumova ET, Stoitsova SR, Paunova-Krasteva TS, Pashova SB, Angelova MB (2012) Copper stress and filamentous fungus Humicola lutea 103—ultrastructural changes and activities of key metabolic enzymes. Can J Microbio 58(12):1335–1343
Luna MAC, Vieira ER, Okada K, Campos-Takaki GM, do Nascimento AE (2015) Copper-induced adaptation, oxidative stress and its tolerance in Aspergillus niger UCP1261. Electron J Biotech 18:418–427
Mani D, Kumar C (2014) Biotechnological advances in bioremediation of heavy metals contaminated ecosystems: an overview with special reference to phytoremediation. Int J Environ Sci Technol 11:843–872
McClements DJ (2007) Analysis of proteins. Dissertation, University of Massachusetts Amherst
Ohkawa H, Ohishi N, Yagi K (1979) Assay for lipid peroxides in animal tissues by thiobarbituric acid reaction. Anal Biochem 95:351–358
Papapostolou I, Sideri M, Georgiou CD (2014) Cell proliferating and differentiating role of H2O2 in Sclerotium rolfsii and Sclerotinia sclerotiorum. Microbiol Res 169:527–532
Rózycki H (1992) Effect of heavy metals (Pb, Zn, Cu and Cd) on germination of conidia of Cylindrocarpon destructans (Zinssm.) Scholten. Zbl Mikrobiol 147:261–269
Rózycki H (1993) Effect of heavy metals (Pb, Zn, Cu and Cd) on mycelial growth of Cylindrocarpon destructans (zinssm.) Scholten. Zbl Mikrobiol 148:265–275
Rusina Y, Kaloyan N, Christov L, Petrova P (2004) Antioxidative enzymes in barley plants subjected to soil flooding. Environ Exp Bot 51:93–101
Saitou N, Nei M (1987) The neighbor-joining method: a new method for reconstructing phylogenetic trees. Mol Biol Evol 4:406–425
Todorova D, Nedeva D, Abrashev R, Tsekova K (2008) Cd(II) stress response during the growth of Aspergillus niger B77. J Appl Microbiol 104:178–184
Wang L, Chen DW, Wang H, Liu ZP (2009) Effects of lead and/or cadmium on the expression of metallothionein in the kidney of rats. Biol Trace Elem Res 129:190–199
Willetts HJ (1971) The survival of fungal sclerotia under adverse environmental conditions. Biol Rev 46:387–407
Zafar S, Aqil F, Ahmad I (2007) Metal tolerance and biosorption potential of filamentous fungi isolated from metal contaminated agricultural soil. Bioresour Technol 98:2243–2257
Zhao WJ, Han JR, Long DD (2015) Effect of copper−induced oxidative stress on sclerotial differentiation, endogenous antioxidant contents, and antioxidative enzyme activities of Penicillium thomii PT95. Ann Microbiol 65:1505–1514
Acknowledgements
This work was supported by the Chinese National Natural Science Fund (grant no. 31070048)
Author information
Authors and Affiliations
Corresponding author
Ethics declarations
Conflict of interest
The authors declare that they have no conflict of interest.
Rights and permissions
About this article
Cite this article
Long, DD., Fu, RR. & Han, JR. Tolerance and stress response of sclerotiogenic Aspergillus oryzae G15 to copper and lead. Folia Microbiol 62, 295–304 (2017). https://doi.org/10.1007/s12223-017-0494-y
Received:
Accepted:
Published:
Issue Date:
DOI: https://doi.org/10.1007/s12223-017-0494-y